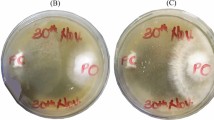

Abstract
THE swarming of species of Proteus on solid culture media is a well known and often troublesome phenomenon (Fig. 1). It may be suppressed in various ways1, and considerable attention has been paid to possible factors involved in this peculiar zonal growth2–8. This communication reports the effect of activated charcoal on the swarming of five strains of Proteus. The strains used were P. vulgaris C and B 11 and P. mirabilis 12, 8268, and NCTC 5887.
This is a preview of subscription content, access via your institution
Access options
Subscribe to this journal
Receive 51 print issues and online access
$199.00 per year
only $3.90 per issue
Buy this article
- Purchase on SpringerLink
- Instant access to the full article PDF.
USD 39.95
Prices may be subject to local taxes which are calculated during checkout
Similar content being viewed by others
References
Naylor, P. G. D., J. App. Bact., 27, 422 (1964).
Hoeniger, J. F. M., J. Gen. Microbiol., 40, 29 (1965).
Hoeniger, J. F. M., J. Bact., 90, 275 (1965).
Hughes, W. H., J. Gen. Microbiol., 17, 49 (1957).
Klieneberger-Nobel, E., J. Hyg., Camb., 45, 410 (1947).
Kopp, R., and Müller, J., App. Microbiol., 13, 950 (1965).
Lominski, I., and Lendrum, A. C., J. Path. Bact., 59, 688 (1947).
Russ-Münzer, A., Zbl. Bakt. (l. Orig.), 133, 214 (1935).
Author information
Authors and Affiliations
Rights and permissions
About this article
Cite this article
SMITH, D., ALWEN, J. Effect of Activated Charcoal on the Swarming of Proteus. Nature 212, 941–942 (1966). https://doi.org/10.1038/212941a0
Issue date:
DOI: https://doi.org/10.1038/212941a0